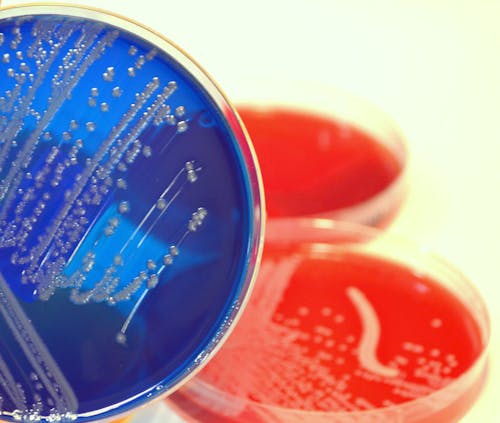
Il sorprendente ruolo dei batteri intestinali nella progressione del mieloma multiplo

Ultimo aggiornamento: 28 luglio 2022
Titolo originale dell'articolo: Microbiota-driven interleukin-17-producing cells and eosinophils synergize to accelerate multiple myeloma progression
Titolo della rivista: Nature Communication
Data di pubblicazione originale: 3 dicembre 2018
I risultati di uno studio condotto principalmente con i topi mostrano il rapporto tra microbiota intestinale, modulazione del sistema immunitario e progressione del mieloma multiplo. Lo studio apre interessanti prospettive in ambito prognostico e terapeutico.
È sempre più chiaro che i batteri intestinali giocano un ruolo importante nella modulazione di malattie non solo dell’intestino. Il gruppo di ricercatori diretti dall'immunologo Matteo Bellone all'Ospedale San Raffaele di Milano si sono chiesti se il microbiota possa essere in qualche modo associato al mieloma multiplo, un tumore che colpisce le cellule del sistema immunitario responsabili della produzione di anticorpi. I ricercatori hanno scoperto che, almeno in topi con mieloma multiplo, alcuni batteri intestinali favoriscono la progressione della malattia dalla fase asintomatica a quella sintomatica, mentre altri la rallentano. Queste osservazioni, ottenute grazie al sostegno di AIRC e con il lavoro in prima linea delle ricercatrici Arianna Calcinotto e Arianna Brevi, sono state rese note sulla rivista Nature Communications.
“Quando abbiamo importato dagli Stati Uniti alcuni topi di un ceppo modificato geneticamente per favorire lo sviluppo di mieloma multiplo, ci siamo accorti che nei nostri animali la malattia compariva più tardivamente rispetto a quelli, dello stesso tipo, rimasti negli USA” racconta Bellone. “Abbiamo sospettato un ruolo in differenze nel microbiota intestinale e i risultati degli esperimenti condotti hanno confermato l'ipotesi”. A promuovere la più rapida progressione del mieloma nei topolini americani sembra essere stato un batterio chiamato Prevotella heparinolytica, assente in quelli italiani. Il batterio Prevotella melaninogenica pare invece che abbia avuto un effetto opposto, rallentando la comparsa della malattia.
I ricercatori hanno scoperto che i batteri esercitano questi effetti modulando l'attivazione di due tipi di cellule immunitarie responsabili del rilascio di molecole infiammatorie come l'interleuchina 17 (IL-17). Bloccando queste molecole o modificando la flora batterica degli animali era possibile rallentare la progressione della malattia. Nei pazienti con mieloma multiplo asintomatico i ricercatori hanno verificato che in effetti esiste un'associazione tra i livelli di IL-17 nel midollo e la velocità della progressione. Questi risultati aprono interessanti prospettive in ambito prognostico e terapeutico. Prima però occorrerà ottenere ulteriori conferme in studi con i pazienti: a breve dovrebbe partire un primo studio clinico proprio per chiarire meglio i rapporti tra microbiota intestinale, interleuchina-17 e mieloma multiplo negli esseri umani.
Nome Cognome